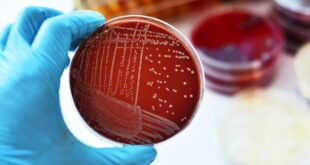

O Ministério Público Federal (MPF), através da Procuradoria da República no Rio de Janeiro, solicitou o arquivamento de uma “Notícia de Fato” que apurava supostos desvios de verbas, superfaturamento e má gestão no Hospital Natividade, que se trata de entidade filantrópica. A decisão, que foi homologada pelo Subprocurador-Geral da República, Paulo Queiroz, considerou as alegações iniciais como “ilações e narrativas …
Leia Mais »Daily Archives: 9 de outubro de 2025
Funcionário da limpeza urbana é atropelado no Centro de Natividade
Um homem – funcionário da companhia que presta serviços de recolhimento de lixo urbano – foi atropelado no final da manha desta quinta-feira (09), na Avenida Amaral Peixoto, Centro de Natividade. De acordo com testemunhas, ele recolhia os detritos (caminhão compactador), quando teria sido atingido por uma moto Honda XRE 300, em frente ao Santuário Diocesano. Tanto ele, como o …
Leia Mais »Polícia prende suspeito de tentativa de assalto a pizzaria em Aperibé
A ação rápida da Polícia Militar resultou na prisão de um homem suspeito de tentar assaltar uma pizzaria em Aperibé, na tarde desta quarta-feira (08/10). Segundo o relato da vítima, o criminoso chegou ao estabelecimento de capacete com a viseira aberta, pediu uma sacola e, em seguida, anunciou o assalto, fazendo ameaças ao comerciante. No entanto, o suspeito fugiu sem …
Leia Mais »Pádua confirma caso de meningite em escola municipal
As Secretaria Municipais de Educação e Saúde de Santo Antônio de Pádua confirmaram nesta quarta-feira (08) a ocorrência de um caso de meningite bacteriana na rede municipal de ensino. O laudo laboratorial e o parecer técnico indicaram que o agente causador é a bactéria Streptococcus pneumoniae. As autoridades de saúde emitiram uma nota para tranquilizar a comunidade, ressaltando que não …
Leia Mais »Integrantes do “tribunal do tráfico” são presos em Italva
Uma operação conjunta das Polícias Civil e Militar resultou na prisão de três homens em Italva na manhã desta quarta-feira (08), acusados de participar de uma sessão de tortura qualificada, que a polícia suspeita estar ligada a um “tribunal do tráfico” local. A ação foi coordenada pelo delegado Rivelino Bueno, titular da 148ª DP, com o suporte de agentes da …
Leia Mais » Natividade FM
Natividade FM